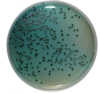

Gram Negative Rods Flashcards
(8 cards)
1
Q
Gram negative cocci
A
-Neisseria meningitidis -Neisseria gonococcus
2
Q
Gram negative bacilli-small bacilli
A
Acinetobacter Hemophilus
3
Q
Gram Negative Bacilli
A
-E. Coli -Klebsiella -Pseudomonas -bacteroides
4
Q
Selective and indicator media
A
-MacConkey -Hektoen Enteric
5
Q
MacConkey
A
- Lactose (negative, positive, intense positive)
- All stool samples go into this agar

6
Q
Hektoen Enteric
A
-Tests for Shigella vs Salmonella
7
Q
Anaerobic gram negatives
A
- Bacteroides (Poop)
- Fusobacterium (mouth)
8
Q
Oxidase Test
A
Negative: Enterobacteriaceae
Lactose Fermentation Test (+/-)
Positive:
Water bugs, Animal Bite
Ox-; Lac - Non enterobacteriaceae